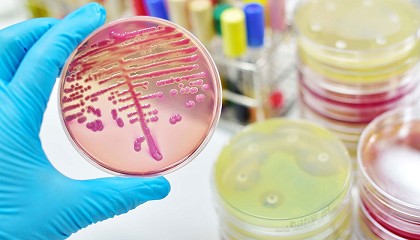

Resultados de la búsqueda "iat"
eMobility Expo 2024 reunirá a más de 6.000 directivos en Valencia en febrero en busca de socio industrial, energético y tecnológico - 24/11/2023

IATA, AirEuropa, Piaggio, Railgroup, Indra, Renfe, Jaguar Land Rover, Total Energies, la agrupación Future Fast Forward o Stellantis, así como representantes institucionales del Ministerio de Transporte y Movilidad Sostenible y de la Generalitat
El CMJ premia las trayectorias jamoneras de su duodécima edición - 29/05/2024

IATA-CSIC, cuya influencia en la ciencia de los alimentos es global. Toldrá es un líder reconocido en el estudio de los procesos bioquímicos en la fabricación de productos cárnicos
Un estudio preliminar muestra mayor toxicidad en bolsas compostables que en las de plástico convencional - 04/10/2023

IATA-CSIC), y de la plataforma Susplast, y publicado en Journal of Hazardous Materials, se realizó una extracción de las bolsas para analizar los compuestos tóxicos que podían ser liberados
Desarrollan un nuevo film de acolchado agrícola sostenible y activo en la protección del cultivo - 11/12/2023

IATA) y por Luis Cabedo Mas, integrante del grupo de investigación PIMA - Polímers i Materials Avançats de la Universitat, tiene como finalidad el desarrollo de un film biodegradable y agrocompostable
BCL y Aena impulsan la digitalización para el sector de la carga aérea de Barcelona - 27/05/2024

IATA y cumple con iniciativas como e-Freight y e-AWB, añadiendo que incluye a las líneas aéreas y, en un futuro, a las compañías de handling de segunda línea
Cultivos emergentes en el mediterráneo: una estrategia para afrontar el cambio climático. Red NutriCrop - 04/10/2024

IATA-CSIC (Instituto de Agroquímica y Tecnología de Alimentos, Valencia); UVa, (Universidad de Valladolid), Ig (Instituto de la Grasa-CSIC); CIAL (Instituto de Investigación en Ciencias de la Alimentación); y iii) la inmunonutrición
En marcha el primer corredor digital de carga aérea Madrid-Montevideo - 10/06/2022

IATA. Redacción Interempresas El pasado 18 de mayo se inició el primer envío aéreo digitalizado en su totalidad desde Europa a Latinoamérica, empleando la solución Usyncro para dar visibilidad y agilizar
Elegir bien el transporte, conocer la normativa y buscar alojamientos pet friendly, las recomendaciones del COVB a la hora de viajar con mascotas - 04/07/2024

IATA (Asociación Internacional de Transporte Aéreo). Algunas aerolíneas permiten llevar animales hasta cierto peso en la cabina, con un sistema adecuado de retención, pero lo habitual en autobuses y aviones
Un estudio aborda la función de las bacterias intestinales para desarrollar nuevos probióticos - 21/09/2023
IATA), ha publicado recientemente en la revista Nature un artículo que aborda el papel que podrían tener las bacterias intestinales en el desarrollo de probióticos de nueva generación para proteger
Mecanizado de materiales difíciles en aeronáutica - 19/09/2023

IATA (Asociación de Transporte Aéreo Internacional), se espera que las aerolíneas estén en números negros en 2023, por primera vez desde 2019. Los fabricantes de aviones quieren aumentar su número
Itene e IATA-CSIC lanzan la XIV edición del Máster online en Tecnología de Envases y Embalajes - 09/06/2021

IATA-CSIC lanzan la XIV edición del Máster online en Tecnología de Envases y Embalajes - 09/06/2021: Itene e IATA-CSIC lanzan la XIV edición del Máster online en Tecnología de Envases
Líderes de destacadas multinacionales expondrán los avances de la movilidad del futuro en eMobility Expo World Congress - 28/02/2023

IATA, o Clúster AEMES, entre muchas otras. Este encuentro global, que ya tiene las acreditaciones abiertas, contará con nueve foros verticales y cuatro agendas específicas entre las que destaca el foro
Sustituyen grasa saturada por oleogeles de aceite de girasol y oliva en la elaboración de bollería - 21/06/2022

IATA), centro de investigación del Consejo Superior de Investigaciones Científicas (CSIC), ha conseguido la sustitución total de grasas sólidas como mantequilla, margarina, grasa de palma y grasa de coco por oleogeles
Margarita de Gregorio, presidirá la Alianza para la Sostenibilidad del Transporte Aéreo - 26/03/2024

AESA, Air Europa, Air Nostrum, AOP, Binter, Boeing, CEOE, Ecodes Ecología y Desarrollo, Enaire, Exolum, IATA, Iberia, Senasa, Tedae, Transport and Environment, la Universidad Politécnica de Madrid (UPM) y Vueling.
AZA Logistics, operador logístico 4PL - 13/11/2023

IATA para gestionar sus cargas aéreas. Equipo de Ingeniería y Farmacia Dedicado Disponemos de un equipo de ingeniería de procesos y calidad dedicado únicamente para los sectores de farma, cosmética
Consumir horchata natural produce cambios beneficiosos en la microbiota intestinal - 09/05/2022

IATA-CSIC ya publicó un estudio que desvelaba la mayor presencia de nutrientes en la horchata natural sin pasteurizar. Ahora, inspirados por otros trabajos realizados por la investigadora del IATA
Oleogeles para sustituir grasas en la elaboración de embutidos - 21/01/2022

IATA), y Marta Martínez Sanz, investigadora del Instituto de Investigación en Ciencias de la Alimentación (CIAL, CSIC - Universidad Autónoma de Madrid). Redacción Interempresas Los oleogeles son materiales que contienen un aceite
El camino hacia la digitalización en la industria aeroespacial. La recuperación del sector aéreo tras de la pandemia - 29/09/2022

IATA), la principal asociación del sector predice una pérdida neta de U$11,6 mil millones para este 2022. Este número de todas maneras es bastante menor que la pérdida
Observan una misma adaptación genética en dos levaduras usadas en la fermentación del vino - 20/12/2021

IATA-CSIC ) ha descubierto los mecanismos genéticos por los que Saccharomyces uvarum , una de las levaduras empleadas para elaborar vino, actúa en la fermentación del mismo. Redacción Interempresas Los investigadores
VINEBOX crea la primera bobina de papel a partir de la valorización de residuos de poda de vid - 08/02/2024

IATA-CSIC), el Instituto Tecnológico del Embalaje, Transporte y Logística (Itene), y la empresa Athisa, que aporta soluciones para el servicio de recogida y acopio de las podas de sarmiento
